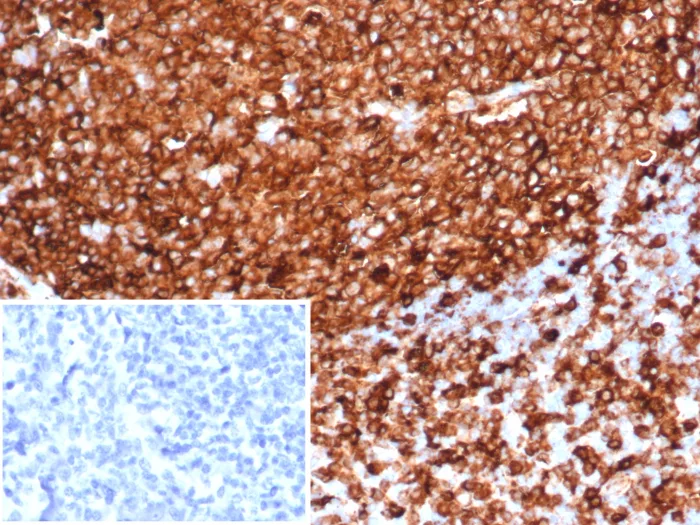

Formalin-fixed, paraffin-embedded human tonsil stained with HLA-DR Recombinant Rabbit Monoclonal Antibody (HLA-DRA/6839R). Inset: PBS instead of primary antibody; secondary only negative control.
This MAb reacts with the beta-chain of HLA-DR antigen, a member of MHC class II molecules. Â �It does not cross react with HLA-DP and HLA-DQ. The L243 antibody recognizes a different epitope than the HLA-DRA/6839R monoclonal antibody, and these antibodies do not cross-block binding to each other’s respective epitopes. HLA-DR is a heterodimeric cell surface glycoprotein comprised of a 36kDa alpha (heavy) chain and a 28kDa beta (light) chain. It is expressed on B-cells, activated T-cells, monocytes/macrophages, dendritic cells and other non-professional APCs. In conjunction with the CD3/TCR complex and CD4 molecules, HLA-DR is critical for efficient peptide presentation to CD4+ T cells. It is an excellent histiocytic marker in paraffin sections producing intense staining. True histiocytic neoplasms are similarly positive. HLA-DR antigens also occur on a variety of epithelial cells and their corresponding neoplastic counterparts.
There are no reviews yet.